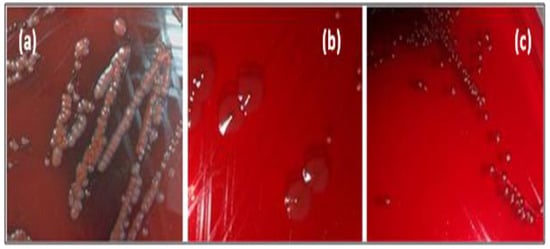

Abstract
Essential oils from aromatic and medicinal plants have many bioactive compounds known for their important biological activities mainly their antibacterial effects. Here we evaluated qualitatively and quantitatively the biofilm formation capability of pathogenic bacterial strains (n = 8). Then, we investigated the antibacterial, antibiofilm, antiquorum-sensing, and antiswarming efficacy of Origanum vulgare essential oil (EO) and terpinene-4-ol. Our results revealed that EO exhibited a more potent inhibitory effect against the tested strains. While the terpinene-4-ol was found to be more effective against developed Staphylococcus aureus biofilm. Regarding the anti quorum-sensing activity, we noticed that O. vulgare displayed better inhibition percentages in violacein production even at a low concentration (MIC/4). Additionally, this EO showed better inhibition of Pseudomonas aeruginosa PAO1 migration in comparison with the terpinene-4-ol. Our findings revealed that using pure O. vulgare EO demonstrated better competitive effects against pathogenic bacteria with a different mode of action when compared to the terpinene-4-ol. Hence, exploration and development of efficient anti-infection agents from natural resources such as full EOs represent promising tools in anti-infective therapy.
1. Introduction
Pathogenic bacteria are characterized by their ability to produce several virulence factors. One example is, biofilm formation, which provides them protection against the host immune system defense and allows for the acquisition of significant resistance to various antimicrobials [1]. This form of subsistence, well spread in natural ecosystems as well as in medical and industrial area, afford a solid inter-bacterial contact [2]. Numerous pathogenic bacteria ensure the control and monitoring of biofilm formation under a bacterial communication system known as quorum sensing (QS) [3]. In fact, numerous pathogenic bacteria have the ability to control the expression of their virulence factors through the QS system [4], along with the production of secondary metabolites and stress adaptation mechanisms [5].
One of the recent approaches in antibiotic therapy and biofilm dispersal is to target the bacterial QS system [6]. Therefore, developing innovative therapeutic measures based on novel antibiofilm agents with anti-QS properties are needed. Essential oils (EOs), well known for their bioactive compounds, have previously been proven to be effective in eradicating a wide range of pathogenic microorganisms [7]. Origanum vulgare L. EO has been extensively studied for its strong activity against many types of microorganisms due to the presence of the terpinene-4-ol, an oxygenated monoterpene [8,9,10]. This compound has strong antibacterial activity against several Gram-positive and negative species such as Staphylococcus aureus, Bacillus subtilis, Enterococcus faecalis, Escherichia coli, Pseudomonas aeruginosa, and other pathogenic microorganisms [11,12].
The present study aims to assess the biofilm formation ability of various pathogenic bacteria and to compare the antibacterial and antivirulence effects of O. vulgare EO and its main compound (terpinene-4-ol) against the studied bacteria.
2. Materials and Methods
2.1. Chemical Composition Analysis (GC–EIMS)
GC-EIMS analyses were performed according to the protocols previously described by Davies (1990) and Adams (1995) based on the calculation of the retention times using the n-alkanes series (C8–C23) [13,14].
2.2. Tested Agents and Microorganisms
The EO of O. vulgare and the terpinene-4-ol were purchased from Huiles & Sens (Entrechaux, France). Reference strains (Chromobacterium violaceum ATCC 12472, Pseudomonas aeruginosa PAO1, Escherichia coli ATCC 35218, Salmonella enterica CECT 443, Shigella flexeneri CECT 4804, Staphylococcus aureus ATCC 6538, Bacillus subtilis CIP 5265, Vibrio vulnificus CECT 529, and Listeria monocytogenes CECT 933) were procured from American Type Culture Collection (ATCC, Virginia, USA), Spanish Type Culture Collection (CECT, Valencia, Spain), and Institute Pasteur Collection (CIP, Paris, France).
2.3. Disk Diffusion Assay
The activity of O. vulgare EO and Terpinene-4-ol was evaluated against four Gram negative (P. aeruginosa PAO1, E. coli ATCC 35218, S. enterica CECT 443, S. flexeneri CECT 4804) and four Gram-positive (S. aureus ATCC 6538, B. subtilis CIP 5265, V. vulnificus CECT 529, and L. monocytogenes CECT 933) bacteria, following a standard agar disk diffusion assay [15]. An inoculum of 0.5 McFarland was prepared for each strain and then swabbed onto the surface of Muller Hinton (MH, Bio-rad, Marnes-la-Coquette, France) agar. Whatman discs (Bio-rad, Marnes-la-Coquette, France) were impregnated with 10 μL of the EO and the compound, and then placed onto the surface of inoculated plates (Bio-rad, Marnes-la-Coquette, France). Gentamicin discs (Bio-rad, Marnes-la-Coquette, France) were used as a positive control. After 24 h of incubation at 37 °C, the diameters of inhibition zones (ZOI, in mm) were measured. All experiments were repeated three times.
2.4. Minimum Inhibitory and Minimum Bactericidal Concentrations
The minimum inhibitory concentration (MIC) values for O. vulgare EO and terpinene-4-ol against each strain were determined by the broth dilution method [16]. All pathogens were cultured for 24 h and their optical density was adjusted to 0.5 McFarland standards. The tested agents were transferred to sterile 96-well microtiter plates. The inoculum (10 μL) of each strain was added to each well. MIC was defined as the concentration that completely inhibited visible cell growth during a 24 h incubation period at 37 °C. To determine the minimum bactericidal concentration (MBC) values, 10μL of each well medium with no visible growth was removed and pour plated with MH agar. After 24h of incubation at 37 °C, the number of surviving organisms was determined as CFU/mL [17].
2.5. Biofilm Formation Ability
The ability to produce slime was carried out by culturing each bacterium on Congo Red Agar (CRA) as previously described [18]. After aerobic incubation at 37 °C for 24 h, strains with black colonies were identified as slime positive, while red colonies bacteria were classified as slime-negative strains [18].
Qualitative biofilm formation on glass surfaces was determined according to the protocol previously described by Davenport et al. (1986) [19]. Each strain was tested at least three times and biofilm production by each isolate was interpreted as negative, weak (1+), moderate (2+), or strong (3+).
Quantitative biofilm production by tested strains was assessed using crystal violet staining assay as described previously [20]. Overnight bacterial culture grown in BHI (Bio-Rad, Marnes-la-Coquette, France) were diluted (1:100) in BHI with 2% glucose (w/v, (Bio-rad, Marnes-la-Coquette, France) and then incubated on 96-well tissue culture plates (Nunc, Roskilde, Denmark) for 24h at 37 °C. Adherent bacteria were stained with 1% crystal violet (Merck, Paris, France) for 5 min after their fixation with 95% ethanol (Bio-rad, Marnes-la-Coquette, France). The optical density of each well of the dry microplates was measured at 570 nm (OD570) using an automated reader (Bio-rad, Marnes-la-Coquette, France) and the biofilm formation was interpreted as highly positive (OD570 ≥ 1), low positive (0.1 ≤ OD570 < 1), and negative (OD570 < 0.1).
2.6. Antiadhesion Effect
The antiadhesion properties of O. vulgare EO and terpinene-4-ol were tested according to the protocol of Saising et al. [21]. A 100 μL aliquot of the bacterial growth in BHI supplemented with 2% glucose was transferred to a microtiter plate (Bio-rad, Marnes-la-Coquette, France) and added with 100 μL of different inhibitory concentration (1/16 to 1 × MIC) of the tested agents. After incubation for 24h at 37 °C, the supernatant was discarded and crystal violet (CV) stained biofilm cells were determined at 570nm using a microplate reader (Bio-rad, Marnes-la-Coquette, France).
2.7. Reduction of Biofilms Growth and Development
The reduction in biofilms developed for 48 h at 37 °C by O. vulgare EO and terpinene-4-ol was evaluated as described previously [22]. A range of concentrations (1 × MIC, 2 × MIC, and 4 × MIC) of the selected agents were added to each well of the microplate per well and then incubated for 24 h. After treatment and staining (CV) assay, the biofilm biomass was measured by the absorbance of CV at 570 nm. The percentage of biofilm eradication was determined as:
[(OD growth control—OD sample)/OD growth control] × 100.
2.8. Antiquorum Sensing Activity
The qualitative analysis studied the reduction in violacein pigment. An overnight culture (10 μL) of C. violaceum (adjusted to 0.4 OD at 600 nm) was added into sterile microtiter plates containing 200 μL of LB broth and incubated at 30 °C in the presence and absence of various concentrations of tested agents (MIC = 10 mg/mL until MIC/32 = 0.3125 mg/mL). LB broth containing C. violaceum ATCC 12472 was used as a positive control [23]. The percentage of violacein reduction was calculated by following formula:
Violacein inhibition (%) = (OD585 nm Control—OD585 nm Sample)/OD585 nm Control.
2.9. Antiswarming Activity
An overnight culture of P. aeruginosa PAO1 strain (5 μL, 0.4 OD at 600 nm) was utilized to inoculate the swarming agar medium (1% peptone, 0.5% NaCl, 0.5% agar, and 0.5% of filter-sterilized D-glucose) (Bio-rad, Marnes-la-Coquette, France) at three different concentrations of test agents (50, 75 and 100 μg/mL). The plates were incubated for 16 h at 30 °C. The decrease in swarming was interpreted by measuring the swarm zones of the bacterial cells after 16 h [24].
3. Results
3.1. Essential oil Composition
The chemical composition of O. vulgare EO is summarized in Table 1.

Table 1.
Essential oil composition (%) of Origanum vulgare essential oil.
Twenty-two components with different percentages were identified using HP5 capillary column according to their elution time. O. vulgare EO was rich in Guaiacol–ρ-vinil (68.67%), p-Cymene (4.6%), and β-ionol (3.16%). Other relevant components were terpinen-7-ol (2.57%) and linalool (2.3%). The structures of the major compounds are represented in Figure 1.

Figure 1.
Sharper image structure of the main compounds identified in O. vulgare EO by GC-MS technique. Numbers are same listed in Table 1.
3.2. Antibacterial Activity
Antibacterial effects are reported as inhibition zones, and in vitro activity as MIC and MBC. The obtained results using the disc diffusion method recorded in MH agar are summarized in Table 2.

Table 2.
Antibacterial activity of O. vulgare EO and the terpinene-4-ol against pathogenic bacteria.
The EO of O. vulgare was active against all the tested strains with an inhibition zone ranging from 10.33 ± 0.57 mm to 41.66 ± 0.57 mm. Its zone of inhibition is larger to the size of the positive control antibiotic (Gentamicin) zone (Exception for P. aeruginosa and S. aureus). Terpinene-4-ol was found to be active again six pathogenic strains, with weak inhibition effect against P. aeruginosa PAO1 (less than 8 mm). However, no activity of this compound was observed against B. subtilis CIP 5265.
Considering the MIC and MBC values, both tested substances present a bacteriostatic effect against all tested pathogens at a concentration of 0.048 mg/mL. The MBC values of O. vulgare EO were found to be 1.562 mg/mL for all strains excepting P. aeruginosa PAO1 (50 mg/mL). The terpinene-4-ol exhibited MBC values weaker than the EO, ranging between 3.125 and 12 mg/mL (Table 2).
3.3. Biofilm Formation Activity
Amongst tested strains, five out of eight bacterial pathogens (62.5%) displayed positive (black colony) and variable phenotype (black center) over CRA plates (Figure 2), indicating slime production (Table 3).
Figure 2.
Different morphotypes of pathogenic strains cultivated on CRA. (a): negative morphotype, (b,c): positive morphotype.

Table 3.
Slime production and adhesive properties of selected pathogenic strains.
Qualitative evaluation of biofilm formation potential on glass tube showed that only S. aureus were highly adherent (noted +++), five strains were moderately adherent (noted ++), and only two strains (B. subtilis and S. enterica) were weakly adherent (noted +, Table 3). The results of quantitative biofilm formation ability evaluated with CV staining assay revealed that among the tested bacteria, only S. aureus ATCC 6538 strain was highly biofilm positive (OD570 ≥ 1) over polystyrene surfaces (Table 3). Other strains showed low-grade biofilm formation (0.1 ≤ OD570 < 1).
3.4. Antibiofilm Activity
The highly biofilm forming strain S. aureus ATCC 6538 was selected for the antibiofilm test. For antiadhesion assay, this bacterium was cultured in microtiter plates for 24 h in the presence of sub-inhibitory concentrations of the tested agents (1/16× to 1 × MIC) and the developed biofilm was stained with crystal violet. At a concentration of 1/8 × MIC, corresponding to 0.006 mg/mL against S. aureus ATCC 6538, the EO exerted an antiattachment effect (OD570 < 1), when compared to the control (untreated cells). However, the antiadhesion effect of the main compound was observed from at a concentration of 1/4 × MIC (Figure 3).

Figure 3.
Biofilm formation of S. aureus ATCC 6538 in the presence of sub-inhibitory concentrations of O. vulgare EO and terpinene-4-ol. Error bars represent standard deviations.
Regarding the antibiofilm effect of O. vulgare EO and the terpinene-4-ol, a mature biofilm (48h) of S. aureus was subjected to various concentrations (MIC, 2 × MIC, 4 × MIC) of the tested agents. O. vulgare EO and terpinene-4-ol were effective against the development of biofilms with percentage reduction values ranging from 10.36% ± 1.95 to 54.05% ± 1.48 and 62.28% ± 1.42 to 70.97% ± 9.65, respectively (Figure 4). We clearly noted that the terpinene-4-ol was more effective against S. aureus biofilm than the essential oil.

Figure 4.
Antibiofilm effect of the O. vulgare EO and terpinene-4-ol against S. aureus ATCC 6538 using the Crystal Violet staining assay. Error bars represent standard deviations.
3.5. Antiquorum Sensing Activity
In order to evaluate the extent of QSI, the violacein pigment production in C. violaceum ATCC 12472, in the absence or presence of O. vulgare EO and terpinene-4-ol at different concentrations was evaluated. Our results revealed that the EO inhibited the violacein production more efficiently, with observed percent inhibition of more than 50%, even at a low concentration (MIC/4). In contrast, terpinene-4-ol could inhibit violacein production only at high concentration (MIC) to an extent of 42.29±0.9 % (Table 4).

Table 4.
Percentage of violacein inhibition using C. violaceum ATCC 12472 strain.
3.6. Antiswarming Assay
As swarming migrations play an important role in QS-mediated biofilm formation in uro-pathogens, such as P. aeruginosa PAO1, we examined the anti-QS potential of O. vulgare EO and terpinene-4-ol against QS dependent swarming motility in this strain. The results obtained indicated that the tested agents inhibited the swarming behavior of the test PAO1 pathogen to different extents. In fact, the percentage of antiswarming activity of the main compound reached 25% independently of the concentration. Unlike the O. vulgare EO, which showed more inhibition level in the migration of PAO1 recording 29.17 ± 4.17% (Table 5).

Table 5.
Effect of O. vulgare EO and terpinene-4-ol on swarming motility of PAO1.
4. Discussion
The QS is an efficient bacterial cell–cell communication process that controls numerous mechanisms, particularly in pathogenic bacteria, including antibiotic production, biofilm formation, and virulence factor secretion [4]. Recently, there has been a rise in attempts to search for and identify novel antimicrobials of natural origins to control the emergence of dreaded pathogens [25]. In the present study, we characterized the biofilm formation ability of eight pathogenic bacteria. Then, we investigated the antibacterial, antibiofilm, antiquorum-sensing, and antiswarming efficacy of O. vulgare essential oil and its main compound Terpinene-4-ol.
The results of the first part of our study conducted on biofilm characterization, determined by different phenotypic assays, revealed that S. aureus strain exhibited the highest biofilm production capability when compared to the rest of the pathogenic bacteria. As largely documented in the literature, this bacterium is well known for its efficacy to colonize various biotic and abiotic surfaces [1,26]. Secretion of extracellular polymeric substance matrix by S. aureus leads to the establishment of a solid structure called microbial biofilm [27]. Such polymers surrounding the bacterial micro-colonies allow them protective effects against various external agents [28]. In fact, the resistance to antibiotics, disinfectants, and host defense systems increases when the bacteria are implicated into the biofilms [29]. Due to the continuous increase in bacterial infection rates related to microbial biofilm, the necessity to search and develop new active substances with low toxicity remain of interest.
In the second part of our investigation, we tested the antibacterial effects of O. vulgare EO and terpinene-4-ol. Observing the results of the agar disc diffusion method, it is possible to conclude that pure EO exhibited the highest inhibition zones against most of the tested strains when compared to the tested compound and the reference antibiotic (Gentamicin). Interestingly, the EO showed 6 times greater inhibitory effect with ZOI ≥ 28 mm [30] which is statistically significant (p ˂ 0.05) when compared to the terpinene-4-ol (4 times stronger inhibitory effect). Additionally, O. vulgare EO showed more efficient bacteriostatic impact against almost all tested strains with an MBC value of 1.562 mg/mL. The differences in the effects of natural substances can be due to the synergism between the minor and major molecules composing the O. vulgare EO, unlike the unique major compound [31,32]. Moreover, these differences might be attributed to the differences in the susceptibility of tested species, since the outer membrane of Gram-negative bacteria are characterized by the presence of lipopolysaccharide molecules, which provide a hydrophilic surface [33]. Accordingly, Gram-positive strains are relatively more sensitive to hydrophobic compounds such as EOs [34].
Since bacterial cell attachment represents a critical essential step in biofilm formation, we tested the effect of sub-inhibitory concentrations of the O. vulgare EO and Terpinene-4-ol against the adhesion of the selected strains. Our result demonstrated that at a concentration of 0.006 to 0.018 mg/mL, corresponding to 1/8 × MIC and 1/4 × MIC, respectively, the tested agents exerted an antiattachment effect against the highly biofilm forming strain (S. aureus 6538). The effects of EOs and their compounds against the adhesiveness of S. aureus have been frequently reported [22,35]. Interestingly, the use of EOs as natural antibacterial agents, for inhibition of cell attachment of pathogenic bacteria represents a strategic way to prevent the establishment and the development of mature resistant biofilm [36]. The result of biofilm eradication showed that terpinene-4-ol was more effective against the development of preformed S. aureus biofilm (p < 0.05), with a percentage of reduction values exceeding 60% even at a concentration of 1 × MIC. Our results are in agreement with previous findings recording the effectiveness of various main compounds from EOs such as 1,8 cineol, thymol, and carvacrol in the eradication of staphylococcal biofilms [35,37,38]. Additionally, the efficacy of EOs, as antibiofilm agents from natural origins, was previously documented against several Gram-positive and Gram-negative bacteria [39].
Biologically active substances that interact with bacterial QS systems attenuating their pathogenicity are known as anti-QS compounds. In this part of our study, we evaluated the anti-QS activity O. vulgare EO and terpinene-4-ol, using C. violaceum ATCC12472 as a biomonitor strain. From this test, it was observed that the EO presented better anti-QS activity (p ˂ 0.05) than the compound in a concentration-dependent manner. The inhibition effect of QS by O. vulgare EO from different origins was reported in previous studies [8,10]. The synergistic effects between all the compounds present in this EO leads to the inhibition of bacterial intercellular communication systems and subsequently affects the ability to form biofilms and produce virulence factors in pathogenic bacteria [40,41].
Bacterial swarming motility is one important virulence factor mediated and regulated by the QS system [42]. Our results revealed that a reduction in swarming motility of PAO1 by tested agents was observed in a different manner. In fact, the EO inhibits the migration of PAO1 at higher concentrations (p ˂ 0.05), whereas the effect of terpinene-4-ol is the same regardless of the concentration. It was reported that sub-MICs of various EOs such as tea tree, eucalyptus, and clove revealed a decrease in swarming motility in P. aeruginosa PAO1 in a concentration-dependent manner [35,38]. Interestingly, the inhibition of swarming migration is a promising strategy to fight against pathogenic bacteria since it represents one of the dreaded virulence factors involved in biofilm formation [24].
5. Conclusions
In summary, O. vulgare EO and terpinene-4-ol exhibit various inhibitory effects against pathogenic bacteria. Considering that O. vulgare EO has the highest antibacterial, antiquorum sensing, and antiswarming potential, it is therefore recommended to be valorized as an efficient antimicrobial agent for the treatment of bacterial infections. More investigations are also necessary to elucidate the biological activities of the main compounds identified in O. vulgare essential oil and their possible use in the industrial formulation of essential oil products.
Author Contributions
Conceptualization, E.N., M.S. and A.M.; methodology, E.N., M.S., A.M., M.A., N.H. and K.F.A.; software, M.S., E.N., N.B. and N.H.; validation, M.S., E.N., A.M., and K.F.A.; writing—original draft preparation, E.N., A.M., M.S., N.B., N.H. and M.A.; writing—review and editing, M.S., E.N., and M.A.; supervision, E.N., A.M. and M.S.; project administration, E.N. and M.S.; funding acquisition, E.N. All authors have read and agreed to the published version of the manuscript.
Funding
This research has been funded by Scientific Research Deanship at University of Haìl—Saudi Arabia through project number RG-21114.
Institutional Review Board Statement
Not applicable.
Informed Consent Statement
Not applicable.
Data Availability Statement
Not applicable.
Conflicts of Interest
No potential conflicts of interest were reported by the authors.
References
- Pozzi, C.; Waters, E.M.; Rudkin, J.K.; Schaeffer, C.R.; Lohan, A.J.; Tong, P.; Loftus, B.J.; Pier, G.B.; Fey, P.D.; Massey, R.C.; et al. Methicillin resistance alters the biofilm phenotype and attenuates virulence in Staphylococcus aureus device-associated infections. PLoS Pathog 2012, 8, 1002626. [Google Scholar] [CrossRef] [PubMed]
- Ratajczak, M.; Kaminska, D.; Dlugaszewska, J.; Gajecka, M. Antibiotic Resistance, Biofilm Formation, and Presence of Genes Encoding Virulence Factors in Strains Isolated from the Pharmaceutical Production Environment. Pathogens 2021, 10, 130. [Google Scholar] [CrossRef] [PubMed]
- Papenfort, K.; Bassler, B.L. Quorum sensing signal-response systems in Gram-negative bacteria. Nat. Rev. Microbiol. 2016, 14, 576–588. [Google Scholar] [CrossRef] [PubMed]
- Rutherford, S.T.; Bassler, B.L. Bacterial quorum sensing: Its role in virulence and possibilities for its control. Cold Spring Harb. Perspect. Med. 2012, 2, 012427. [Google Scholar] [CrossRef]
- Pena, R.T.; Blasco, L.; Ambroa, A.; González-Pedrajo, B.; Fernández-García, L.; López, M.; Bleriot, I.; Bou, G.; García-Contreras, R.; Wood, T.K.; et al. Relationship Between Quorum Sensing and Secretion Systems. Front. Microbiol. 2019, 10, 1100. [Google Scholar] [CrossRef]
- Wu, H.; Moser, C.; Wang, H.Z.; Høiby, N.; Song, Z.J. Strategies for combating bacterial biofilm infections. Int. J. Oral. Sci. 2015, 23, 7. [Google Scholar] [CrossRef]
- Soković, M.; Glamočlija, J.; Marin, P.D.; Brkić, D.; van Griensven, L.J. Antibacterial effects of the essential oils of commonly consumed medicinal herbs using an in vitro model. Molecules 2010, 15, 7532–7546. [Google Scholar] [CrossRef]
- Ramos, S.; Rojas, L.; Lucena, M.; Meccia, G.; Usubillaga, A. Chemical composition and antibacterial activity of Origanum majorana L. essential oil from the venezuelan andes. J. Essent. Oil. Res. 2011, 23, 45–49. [Google Scholar] [CrossRef]
- Govindarajan, M.; Rajeswary, M.; Hoti, S.L.; Benelli, G. Larvicidal potential of carvacrol and terpinen-4-ol from the essential oil of Origanum vulgare (Lamiaceae) against Anopheles stephensi, Anopheles subpictus, Culex quinquefasciatus and Culex tritaeniorhynchus (Diptera: Culicidae). Res. Vet. Sci. 2016, 104, 77–82. [Google Scholar] [CrossRef]
- Fikry, S.; Khalil, N.; Salama, O. Chemical profiling, biostatic and biocidal dynamics of Origanum vulgare L. essential oil. AMB Express 2019, 9, 41. [Google Scholar] [CrossRef]
- Mondello, F.; De Bernardis, F.; Girolamo, A.; Cassone, A.; Salvatore, G. In vivo activity of terpinen-4-ol, the main bioactive component of Melaleuca alternifolia Cheel (tea tree) oil against azole-susceptible and -resistant human pathogenic Candida species. BMC Infect Dis. 2006, 6, 158. [Google Scholar] [CrossRef] [PubMed]
- Hammer, K.A.; Carson, C.F.; Riley, T.V. Effects of Melaleuca alternifolia (tea tree) essential oil and the major monoterpene component terpinen-4-ol on the development of single- and multistep antibiotic resistance and antimicrobial susceptibility. Antimicrob. Agents Chemother. 2012, 56, 909–915. [Google Scholar] [CrossRef] [PubMed]
- Davies, N.W. Gas chromatographic retention indices of monoterpenes and sesquiterpenes on methyl silicon and carbowax 20M phases. J. Chromatogr. 1990, 503, 1–24. [Google Scholar] [CrossRef]
- Adams, R.P. Identification of Essential Oil Components by Gas Chromatography-Mass Spectroscopy; Allured Co.: Carol Stream, IL, USA, 1995. [Google Scholar]
- Perez, C.; Agnese, A.M.; Cabrera, J.L. The essential oil of Senecio graveolens (Compositae): Chemical composition and antimicrobial activity tests. J. Ethnopharmacol. 1999, 66, 91–96. [Google Scholar] [CrossRef]
- Conforti, F.; Statti, G.A.; Tundis, R.; Menichini, F.; Houghton, P. Antioxidant activity of methanolic extract of Hypericum triquetrifolium Turra aerial part. Fitoterapia 2002, 73, 479–483. [Google Scholar] [CrossRef]
- Magina, M.D.; Dalmarco, E.M.; Wisniewski, A., Jr.; Simionatto, E.L.; Dalmarco, J.B.; Pizzolatti, M.G. Chemical composition and antibacterial activity of essential oils of Eugenia species. J. Nat. Med. 2009, 63, 345–350. [Google Scholar] [CrossRef]
- Touati, A.; Achour, W.; Abbassi, M.S.; Ben Hassen, A. Detection of ica genes and slime production in a collection of Staphylococcus epidermidis strains from catheter-related infections in neutropenic patients. Pathol. Biol. 2007, 55, 277–282. [Google Scholar] [CrossRef]
- Davenport, D.S.; Massanari, R.M.; Pfaller, M.A.; Bale, M.J.; Streed, S.A.; Hierholzer, W.J. Usefulness of a test for slime production as a marker for clinically significant infections with coagulase-negative staphylococci. J. Infect. Dis. 1986, 153, 332–339. [Google Scholar] [CrossRef]
- Mack, D.; Bartscht, K.; Fischer, C.; Rohde, H.; de Grahl, C.; Dobinsky, S. Genetic and biochemical analysis of Staphylococcus epidermidis biofilm accumulation. Methods Enzymol. 2001, 336, 215–239. [Google Scholar]
- Saising, J.; Dube, L.; Ziebandt, A.K.; Voravuthikunchai, S.P.; Nega, M.; Gotz, F. Activity of Gallidermin on Staphylococcus aureus and Staphylococcus epidermidis biofilms. Antimicrob. Agents Chemother. 2012, 56, 5804–5810. [Google Scholar] [CrossRef]
- Merghni, A.; Marzouki, H.; Hentati, H.; Aouni, M.; Mastouri, M. Antibacterial and antibiofilm activities of Laurus nobilis L. essential oil against Staphylococcus aureus strains associated with oral infections. Pathol. Biol. 2015, 64, 29–34. [Google Scholar] [CrossRef] [PubMed]
- McLean, R.J.C.; Pierson, L.S., III; Fuqua, C. A simple screening protocol for the identification of quorum signal antagonists. J. Microbiol. Methods 2004, 58, 351–360. [Google Scholar] [CrossRef] [PubMed]
- Packiavathy, I.A.; Priya, S.; Pandian, S.K.; Ravi, A.V. Inhibition of biofilm development of uropathogens by curcumin—An anti-quorum sensing agent from Curcuma longa. Food Chem. 2014, 148, 453–460. [Google Scholar] [CrossRef]
- Chadha, J.; Harjai, K.; Chhibber, S. Repurposing phytochemicals as anti-virulent agents to attenuate quorum sensing-regulated virulence factors and biofilm formation in Pseudomonas aeruginosa. Microb. Biotechnol. 2022, 15, 1695–1718. [Google Scholar] [CrossRef] [PubMed]
- Jabra-Rizk, M.A.; Meiller, T.F.; James, C.E.; Shirtliff, M.E. Effect of farnesol on Staphylococcus aureus biofilm formation and antimicrobial susceptibility. Antimicrob. Agents Chemother. 2006, 50, 1463–1469. [Google Scholar] [CrossRef] [PubMed]
- Otto, M. Staphylococcus colonization of the skin and antimicrobial peptides. Expert Rev. Dermatol. 2010, 5, 183–195. [Google Scholar] [CrossRef] [PubMed]
- Davey, M.E.; O’toole, G.A. Microbial biofilms: From ecology to molecular genetics. Microbiol. Mol. Biol. Rev. 2000, 64, 847–867. [Google Scholar] [CrossRef]
- Kania, R.E.; Lamers, G.E.; Vonk, M.J.; Dorpmans, E.; Struik, J.; Tran Ba Huy, P.; Hiemstra, P.; Bloemberg, G.V.; Grote, J.J. Characterization of mucosal biofilms on human adenoid tissues. Laryngoscope 2008, 118, 128–134. [Google Scholar] [CrossRef]
- Elgayyar, M.; Draughon, F.A.; Golden, D.A.; Mount, J.R. Antimicrobial activity of essential oils from plants against selected pathogenic and saprophytic microorganisms. J. Food Prot. 2001, 64, 1019–1024. [Google Scholar] [CrossRef] [PubMed]
- Chalchat, J.C.; Garry, R.P.; Menut, C.; Lamaty, G.; Malhuret, R.; Chopineauc, J. Correlation between chemical composition and antimicrobial activity of some African essential oils. J. Essent. Oil Res. 1997, 9, 67–75. [Google Scholar] [CrossRef]
- Guerra, F.Q.S.; Mendes, J.M.; Sousa, J.P.; Morais-Braga, M.F.B.; Santos, B.H.C.; Coutinho, H.D.M. Increasing antibiotic activity against a multidrug-resistant Acinetobacter spp. by essential oils of Citrus limon and Cinnamomum zeylanicum. Nat. Prod. Res. 2012, 26, 2235–2238. [Google Scholar] [CrossRef] [PubMed]
- Shakeri, A.; Khakdan, F.; Soheili, V.; Sahebkar, A.; Rassam, G.; Asili, J. Chemical composition, antibacterial activity, and cytotoxicity of essential oil from Nepeta ucrainica L. spp. kopetdaghensis. Ind. Crops Prod. 2014, 58, 315–321. [Google Scholar] [CrossRef]
- Li, Z.H.; Cai, M.; Liu, Y.S.; Sun, P.L.; Luo, S.L. Antibacterial Activity and Mechanisms of Essential Oil from Citrus medica L. var. sarcodactylis. Molecules 2019, 24, 1577. [Google Scholar] [CrossRef]
- Noumi, E.; Merghni, A.; Alreshidi, M.; Haddad, O.; Akmadar, G.; De Martino, L.; Mastouri, M.; Ceylan, O.; Snoussi, M.; Al-Sieni, A.; et al. Chromobacterium violaceum and Pseudomonas aeruginosa PAO1: Models for Evaluating Anti-Quorum Sensing Activity of Melaleuca alternifolia Essential Oil and Its Main Component Terpinen-4-ol. Molecules 2018, 23, 2672. [Google Scholar] [CrossRef]
- Cerca, N.; Martins, S.; Pier, G.B.; Oliveira, R.; Azeredo, J. The relationship between inhibition of bacterial adhesion to a solid surface by sub-MICs of antibiotics and subsequent development of a biofilm. Res. Microbiol. 2005, 156, 650–655. [Google Scholar] [CrossRef]
- Nostro, A.; Roccaro, A.S.; Bisignano, G.; Marino, A.; Cannatelli, M.A.; Pizzimenti, F.C.; Cioni, P.L.; Procopio, F.; Blanco, A.R. Effects of oregano, carvacrol and thymol on Staphylococcus aureus and Staphylococcus epidermidis biofilms. J. Med. Microbiol. 2007, 56, 519–523. [Google Scholar] [CrossRef]
- Merghni, A.; Noumi, E.; Hadded, O.; Dridi, N.; Panwar, H.; Ceylan, O.; Mastouri, M.; Snoussi, M. Assessment of the antibiofilm and antiquorum sensing activities of Eucalyptus globulus essential oil and its main component 1,8-cineole against methicillin-resistant Staphylococcus aureus strains. Microb. Pathog. 2018, 118, 74–80. [Google Scholar] [CrossRef]
- Semeniuc, C.A.; Pop, C.R.; Rotar, A.M. Antibacterial activity and interactions of plant essential oil combinations against Gram-positive and Gram-negative bacteria. J. Food Drug Anal. 2017, 25, 403–408. [Google Scholar] [CrossRef]
- Nazzaro, F.; Fratianni, F.; De Martino, L.; Coppola, R.; De Feo, V. Effect of essential oils on pathogenic bacteria. Pharmaceu 2013, 6, 1451–1474. [Google Scholar] [CrossRef]
- Martínez, A.; Manrique-Moreno, M.; Klaiss-Luna, M.C.; Stashenko, E.; Zafra, G.; Ortiz, C. Effect of Essential Oils on Growth Inhibition, Biofilm Formation and Membrane Integrity of Escherichia coli and Staphylococcus aureus. Antibiotics 2021, 10, 1474. [Google Scholar] [CrossRef]
- Nickzad, A.; Lépine, F.; Déziel, E. Quorum Sensing Controls Swarming Motility of Burkholderia glumae through Regulation of Rhamnolipids. PLoS ONE 2015, 10, e0128509. [Google Scholar] [CrossRef]
Publisher’s Note: MDPI stays neutral with regard to jurisdictional claims in published maps and institutional affiliations. |
© 2022 by the authors. Licensee MDPI, Basel, Switzerland. This article is an open access article distributed under the terms and conditions of the Creative Commons Attribution (CC BY) license (https://creativecommons.org/licenses/by/4.0/).